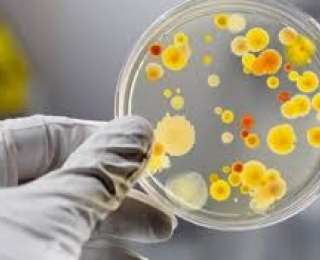

Operativ.am-ը գրում է.
Operativ.am-ը գրում է.
2014 թվականի մարտից աշխարհում դիտվում է էնտերովիրուսային վարակներով պայմանավորված հիվանդությունների աստիճանաբար ակտիվացում: Մի շարք երկրներում Վրաստանում, Մոլդովայում, Ղրղզստանում և այլուր գրանցվել են բռնկումներ:
Մարտից ի վեր Հայաստանի Հանրապետությունում արձանագրվել է էնտերովիրուսային վարակով պայմանավորված շճային մենինգիտի 90 դեպք։
Ամբողջական հոդվածը կարող եք կարդալ այստեղ
Նյութի աղբյուր՝ http://operativ.am/?p=83875/
Կայքում տեղ գտած մտքերն ու տեսակետները հեղինակի սեփականությունն են և կարող են չհամընկնել BlogNews.am-ի խմբագրության տեսակետների հետ:
print
Տպել